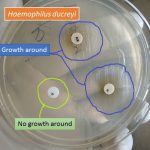
Haemophilus ducreyi

Collection Group: Clinical Bacteriology
Haemophilus ducreyi: Introduction, Morphology, Pathogenesis, Lab Diagnosis and Treatment
Introduction of Haemophilus ducreyi Presumptive Isolation of Haemophilus ducreyi using X,...
Introduction of Haemophilus ducreyi Presumptive Isolation of Haemophilus ducreyi using X,...
Gram Positive Cocci(GPC): In Single, Pairs, Chain and Cluster
 Gram Positive Cocci (GPC) Gram-positive bacteria in Gram stain are...
Gram Positive Cocci (GPC) Gram-positive bacteria in Gram stain are...
Proteus Gram Stain: Introduction, Principle, Procedure and Result Interpretation
 Introduction of Proteus Proteus mirabilis images in Gram stain showing...
Introduction of Proteus Proteus mirabilis images in Gram stain showing...
